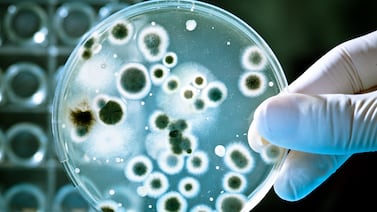

Proveedor costarricense de McDonald’s desde 1991, procesa entre 15 y 17 toneladas de lechuga costarricense y de calidad.
Etiquetas vegetales
El Ministerio de Salud retirará el producto del mercado
El Ministerio de Salud alertó sobre un producto congelado que está contaminado con una bacteria